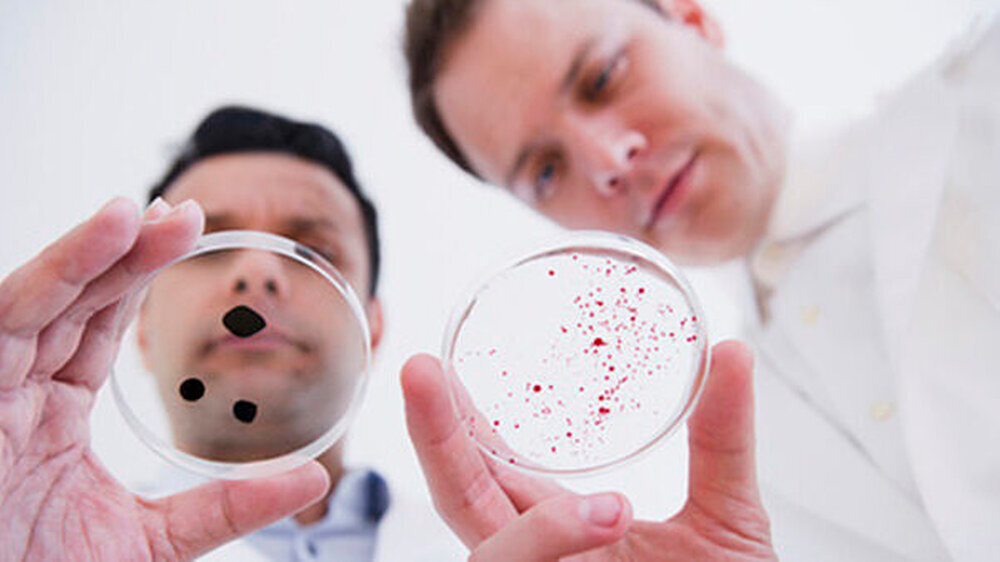

Als Zahnarzt in Biomedizin den Facharzt machen
Dieses bisher einmalige Programm wurde im April 2012 erstmalig mit Absolventen der Medizin und Naturwissenschaften gestartet. Seine Besonderheit ist, dass Mediziner in viereinhalb Jahren parallel den akademischen Ph.D.-Titel erwerben und ihre Facharztausbildung beginnen können.
Die Uni hat dafür mit ihren kooperierenden Kliniken eine Vereinbarung getroffen, die auch eine finanzielle Absicherung der Teilnehmer beinhaltet: Die Kliniken schaffen eine halbe Stelle und die Uni legt ein Stipendium oben drauf.
Halbe Stelle plus ein Stipendium oben drauf
"Das Programm ist deshalb so besonders, weil die Teilnehmer in dieser Zeit ungefähr die Hälfte ihrer Ausbildung zum Facharzt in den Kliniken absolvieren können und in der Laborzeit beim Experimentieren den Bezug zur Arbeit am Krankenbett haben. Das hilft ihnen, translationale Forschung zu erlernen, also später die Forschungsarbeit so einzurichten, dass die Ergebnisse schneller beim Patienten ankommen", erklärt der Zellbiologe und Leiter des Ph.D.-Programms, Prof. Hans-Joachim Lipps. Zielgruppe für das Angebot sind Absolventen, die nach ihrem Studium eine Karriere in der Forschung anstreben.
Vertiefung der Molekularen Medizin
Das Programm ermöglicht Naturwissenschaftlern, Medizinern und Zahnmedizinern die wissenschaftliche Vertiefung in relevanten Fächern der Molekularen Medizin. Dabei können sie sich einer wissenschaftlichen Fragestellung im Rahmen eines mehrjährigen Forschungsprojekts widmen und so die translationale Forschung auf diesem Gebiet fördern.
Die Studierenden legen damit die Grundlage für eine wissenschaftliche Weiterentwicklung und erarbeiten sich ein Forschungsgebiet und Forschungsprofil. Für Mediziner und Zahnmediziner ist das Ph.D.-Programm in die Facharztausbildung integriert.
Aufgenommen werden können Naturwissenschaftler, Mediziner und Zahnmediziner, die ein entsprechendes Studium abgeschlossen haben. Für Bewerber, die eine experimentelle medizinische Dissertation mit mindestens magna cum laude abgeschlossen haben, kann die Studiendauer von durchschnittlich viereinhalb Jahren (inklusive Vorphase) verkürzt werden. Die durchschnittliche Studiendauer von Naturwissenschaftlern (mit Master- oder Diplomabschluss) beträgt zweieinhalb bis drei Jahre. Bewerbungsschluss ist der 30. November 2014.
Weitere Informationen finden Sie unter www.uni-wh.de/gesundheit/phd-dr-rer-nat-programmKontakt: Prof. Dr. Hans-Joachim Lipps, 02302 / 926-144 oder Hans-Joachim.Lipps@uni-wh.de